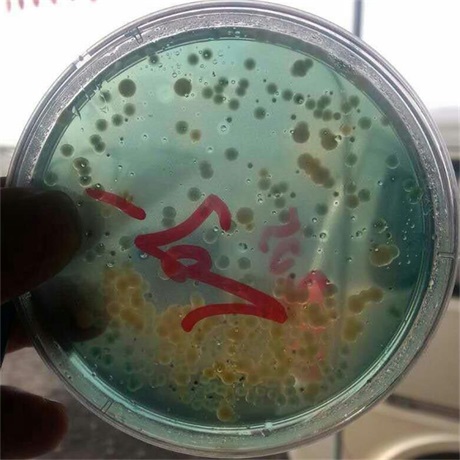

产品名称:菌态
主要成份:多株噬菌蛭弧菌
规 格:1L/20瓶
功能特点:
1、对藻类、水草及虾蟹无任何毒副作用,安全、无刺激。
2、生物消毒,在杀灭有害菌后,还可长时间控制有害菌的繁殖。
3、菌态的高蛋白,可提高养殖动物的体质及免疫力。
使用场景:
1、脱壳期使用,有效降低有害菌的危害;
2、出现弧菌引起的疾病
3、水体老化、分层
4、出现细菌性疾病(如肠炎、黑鳃、肝坏死等)时使用。
【案例】江苏省南通市如东县某虾棚弧菌超标。
处理方案:下午使用菌态(每瓶2亩)化水泼洒。
处理效果:用药24小时后回访,弧菌明显减少。

虾棚
使用菌态前

使用菌态后








